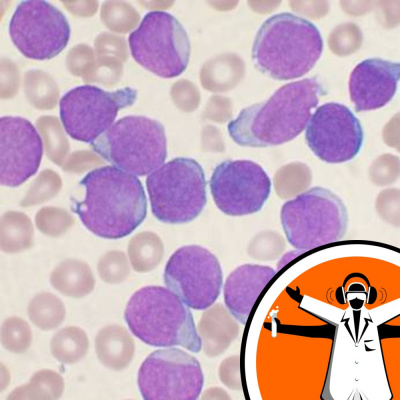
Naked Scientists Special Editions Podcast

Naked Scientists Special Editions Podcast
New Leukemia Therapy
- Author: Vários
- Narrator: Vários
- Publisher: Podcast
- Duration: 0:05:49
- More information
Informações:
Synopsis
Leukemia is a cancer of the white blood cells that normally fight infection. About one person in every 200 will develop the disease, a common form of which is called AML, or acute myeloid leukemia. At the moment it tends to have a relatively poor prognosis and over the past 40 years there have been relatively few new treatments for the disease. A bone marrow transplant is often the only chance an individual has. But this week an international team of scientists led by researchers in the UK announced the discovery of a new way to control the disease by blocking the signals that drive the growth... Like this podcast? Please help us by supporting the Naked Scientists